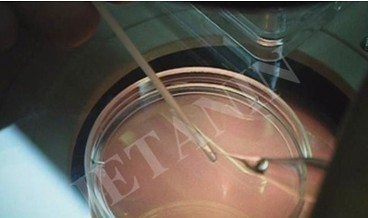

最新热点资讯
泰国试管婴儿医院卵子与胚胎冷冻
发表时间:2014-04-21

在培育试管婴儿过程中,通过促排卵获得多个卵子,再在胚胎实验室与备好的精子结合。通常,受精的胚胎会被放入合适的体外环境中进行培养。此后,取一到三个胚胎植入母亲子宫腔内,等待怀孕。没有移植的健康胚胎可以选择冷冻保存,以备下次被移植,提高怀孕机率。目前,卵子可以冷冻几年再使用。
卵子和胚胎冷冻的优势
降低由于植入太多胚胎导致的双胞胎机率。
减少每次培育试管婴儿需要摧毁的胚胎数量。
通过增加在适当的激素水平周期有可用胚胎进行移植的机会,提高怀孕机率。
对于面临接受化疗风险的女性,可提高她们未来怀孕的机率。患者可以在治病之前先将卵子冷冻保存,因为治疗可能产生副作用,导致绝经或不能生育。
提高可能结婚晚的女性的怀孕机率。
泰国JETANIN辅助生殖研究院采用以下两种方法进行卵子和胚胎冷冻:

1. 慢速冷冻用于冷冻第一至第三天(二细胞-卵裂期)的胚胎,通过慢速平衡降温的方式,提高存活率。
2. 玻璃化冷冻是目前颇受欢迎的方法,采用快速降温的方法,使卵子、胚胎和冷冻保护剂形成玻璃状固体。快速降温可避免冻伤卵子,以及在液体组织形成玻璃状固体的过程中没有冰晶产生,使囊胚阶段的胚胎存活率高于第一种冷冻方式。

关注试管婴儿官方微信帐号:"Y400-066-9158",每日早晚,获取最新试管婴儿资讯。
下一篇: 泰国试管婴儿的染色体技术
立即申请"泰国试管婴儿优惠礼包"
每天公开放10个免费名额
今天还
余最后10个名额
余最后10个名额
网络直接申请试管婴儿套餐
送试管婴儿助孕金3000元
- 秦*生领取礼包成功2016-07-23
- 冯*士领取礼包成功2016-07-23
- 马*红领取礼包成功2016-07-23
- 聂*丽领取礼包成功2016-07-08
- 卢*领取礼包成功2016-07-08
- li*y领取礼包成功2016-07-08
- 邵*宁领取礼包成功2016-06-28
- 梁*悦领取礼包成功2016-06-28
- 蔡*士领取礼包成功2016-06-25
- 李*蔷领取礼包成功2016-06-25
- 曹*娟领取礼包成功2016-06-25
- 樊*晓领取礼包成功2016-06-22
- 李*楠领取礼包成功2016-06-22
- 赵*兰领取礼包成功2016-06-22
- 何*娇领取礼包成功2016-05-25
- 张 *领取礼包成功2016-05-25
- 曹*霞领取礼包成功2016-05-23
- 李*梦领取礼包成功2016-05-16
- 张*珺领取礼包成功2016-05-16
- 王*芳领取礼包成功2016-05-14
- 谭*鑫领取礼包成功2016-05-14
- 穆*龙领取礼包成功2016-05-14
- 方*球领取礼包成功2016-05-13
- 丁*慧领取礼包成功2016-05-13
- 陈*仙领取礼包成功2016-05-13
- 秦*子领取礼包成功2016-05-13
- 洪*兰领取礼包成功2016-05-13
- 杜*生领取礼包成功2016-05-12
- 赵*士领取礼包成功2016-05-12
- 韩*娟领取礼包成功2016-05-12
- 林*子领取礼包成功2016-05-11
- 梁*妹领取礼包成功2016-05-11
- 张*强领取礼包成功2016-05-11
- 文*霞领取礼包成功2016-05-11
- 秦*士领取礼包成功2016-05-11
- 李*花领取礼包成功2016-02-27
- 袁*娟领取礼包成功2016-02-15
- 胡*品领取礼包成功2016-02-15
- 陈*勋领取礼包成功2016-02-15
- 喻*连领取礼包成功2016-02-15
- 秦*生领取礼包成功2016-07-23
- 冯*士领取礼包成功2016-07-23
- 马*红领取礼包成功2016-07-23
- 聂*丽领取礼包成功2016-07-08
- 卢*领取礼包成功2016-07-08
- li*y领取礼包成功2016-07-08
- 邵*宁领取礼包成功2016-06-28
- 梁*悦领取礼包成功2016-06-28
- 蔡*士领取礼包成功2016-06-25
- 李*蔷领取礼包成功2016-06-25
- 曹*娟领取礼包成功2016-06-25
- 樊*晓领取礼包成功2016-06-22
- 李*楠领取礼包成功2016-06-22
- 赵*兰领取礼包成功2016-06-22
- 何*娇领取礼包成功2016-05-25
- 张 *领取礼包成功2016-05-25
- 曹*霞领取礼包成功2016-05-23
- 李*梦领取礼包成功2016-05-16
- 张*珺领取礼包成功2016-05-16
- 王*芳领取礼包成功2016-05-14
- 谭*鑫领取礼包成功2016-05-14
- 穆*龙领取礼包成功2016-05-14
- 方*球领取礼包成功2016-05-13
- 丁*慧领取礼包成功2016-05-13
- 陈*仙领取礼包成功2016-05-13
- 秦*子领取礼包成功2016-05-13
- 洪*兰领取礼包成功2016-05-13
- 杜*生领取礼包成功2016-05-12
- 赵*士领取礼包成功2016-05-12
- 韩*娟领取礼包成功2016-05-12
- 林*子领取礼包成功2016-05-11
- 梁*妹领取礼包成功2016-05-11
- 张*强领取礼包成功2016-05-11
- 文*霞领取礼包成功2016-05-11
- 秦*士领取礼包成功2016-05-11
- 李*花领取礼包成功2016-02-27
- 袁*娟领取礼包成功2016-02-15
- 胡*品领取礼包成功2016-02-15
- 陈*勋领取礼包成功2016-02-15
- 喻*连领取礼包成功2016-02-15
更多












